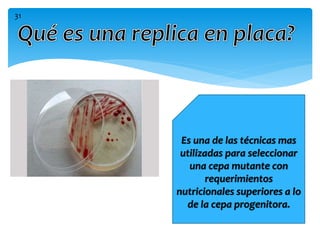
Es una de las técnicas mas
utilizadas para seleccionar
una cepa mutante con
requerimientos
nutricionales superiores a lo
de la cepa progenitora.
31

El documento presenta información sobre conceptos básicos de genética bacteriana, incluyendo la diferencia entre genotipo y fenotipo. Explica características del ADN y ARN, y mecanismos de variación bacteriana como mutaciones espontáneas e inducidas, y recombinación a través de conjugación, transducción y transformación.